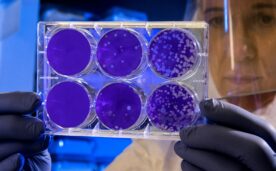

The Chair in Science and Society of the Rafael del Pino Foundation reflects the vocation of its director, Javier García, who for more than a decade has been involved in science communication and in creating a state of opinion on the major issues that concern society. The professor participates in interviews, public debates and hearings and publishes in the general media.
A regular contributor to the World Economic Forum, his publications address topics such as the impact of technology on the future of jobs, the energy transition, the impact of nanotechnology on security, welfare and the economy, new energy alternatives, among others.
Co-author of eight World Economic Forum (WEF) reports on emerging technologies, he participates in various working groups and roundtables, including the Annual Summit in Davos and the Annual Meeting of the New Champions in China. The latest WEF report can be downloaded at here.
-

Javier García at the UC: «Science and magic only differ in that at the end we tell the trick».»
“The only difference between science and magic is that at the end we tell the trick», confesses Javier García Martínez in this interview granted to the University of Cantabria before inaugurating the latest edition of its Summer Courses.
-
La Nación: «If science doesn't listen, it becomes the new inquisition».»
«If it does not change, if it continues with its strict recommendations, it runs the risk of becoming a New Inquisition». This was the opinion of Javier García, Director of the Chair of Science and Society at the Rafael del Pino Foundation, in this interview published in the Argentinean newspaper La Nación.
-

El País: “It is a mistake to divide the world between business and research”.”
In this interview published in the newspaper El País after receiving the ‘Juan de la Cierva’ National Research Award in the area of Technology Transfer, the director of the Chair of Science and Society of the Rafael del Pino Foundation, Javier García, stresses the challenges to place Spain at the forefront of science and...
-

1 in 623
In this opinion article, published in the newspaper La Verdad on 29 October 2020, the Science and Society Chair expert Pablo Artal characterises Spanish science as an eternal unfinished business. "Aged, underfunded and asphyxiated, it survives on the basis of quixotic individualities", says the university professor and physicist specialised in optics and...
-

Scientific American: Bioplastics may be the solution
Every year, Scientific American magazine publishes its special report The top ten emerging technolgies. Rafael del Pino Foundation professor Javier García is a regular contributor to this special publication on disruptive technologies that can change the world. In the 2019 edition, the president-elect of the International Union of Chemistry, Javier García, also...
-

Tribuna El País: The science is not convincing
An article in the newspaper El País in which Professor Rafael del Pino Javier García explains the difficulties encountered by science in offering a truthful and convincing account of science.
-

Tribuna El País: Science against climate change
Opinion article by Jvier García published in El País on 11 December 2019.
-

Tribuna El País: The language of things
Article by Javier García on the historical evolution and usefulness of chemical nomenclature.
-

Nature Chemistry: A common language for chemistry
An article by Rafael del Pino Foundation Professor in which he recounts the historical process by which the chemical elements have been named. Originally published in the scientific journal Nature Chemistry.
-

RNE: "Science has made me freer and happier".
Two interviews with Javier García on Radio Nacional de España.



